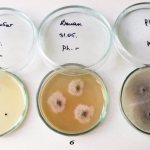
image

Это грибковое заболевание кожи специалисты называют эпидермофитией крупных складок. Типичные для болезни симптомы и традиционные зоны локализации грибка (паховая область и стопы) позволяют уже на ранних стадиях инфицирования определить диагноз с высокой степенью точности и начинать лечение эпидермофитии у мужчин и женщин. В этом случае и те, и другие быстро идут на поправку.
Если же заболевшие относятся к своим проблемам легкомысленно, их болезненное состояние может растянуться не на один год.
Общие сведения
Распространенность микозов (грибковые заболевания) охватывает до 20% населения и растет с возрастом. В возрасте 70 лет этими заболеваниями страдает 50% населения. Отмечается тенденция к увеличению грибковыми заболеваниями кожи и у детей. Рост заболеваемости микозами объясняется возросшим применением антибиотиков широкого спектра действия и увеличением количества больных с иммунодефицитными состояниями. Известны более 500 видов грибов, но какая-то часть из них поражает кожу и ее придатки (волосы и ногти), не затрагивая глубокие ткани. Данная группа патогенов вызывает поверхностные микозы или дерматомикозы. Грибы — возбудители дерматомикозов (их называют дерматофитами), нуждаются в питании органическими соединениями, в данном случае это кератин тканей человека или животных. Дерматофиты высококонтагиозны и передаются от человека к человеку, от животных или попадают на кожу из окружающей среды. К поверхностным микозам относятся микозы стоп, рубромикоз, паховая дерматофития, трихофития, фавус, микроспория.
Для внедрения гриба в кожу и развития заболевания любой локализации имеют значение вирулентность и патогенность возбудителя, а также состояние макроорганизма — это снижение реактивности, возраст, авитаминоз, нарушение обмена веществ и наличие эндокринной патологии. Важное значение имеет состояние кожи — фактор, который способствует инфицированию. Наличие трещин, потертостей, мацерации, порезов, травм, причиненной тесной обувью.
Сегодня мы рассмотрим два дерматомикоза — паховая эпидермофития (она имеет и другое название — окаймленная экзема), вызываемая грибом Epidermophyton floccosum и эпидермофития стоп, которая вызывается Trichophyton mentagrophytes (данный дерматофит может паразитировать и стопах и в области крупных складок). Грибы рода Candida редко самостоятельно приводят к развитию заболевания — чаще их обнаруживают как микс-инфекцию с дерматофитами.
Безусловно, среди дерматомикозов на первом месте стоят микозы стоп и ногтей (онихомикозы). По распространенности среди взрослых они превалируют над другими инфекционными поражениями кожи. Дерматофитии стоп встречаются в 3 раза чаще, чем других локализаций.
Диагностика
Диагностикой и лечением грибка в паховой области занимаются врачи-дерматологи и микологи. После сбора анамнеза заболевания и выслушивания жалоб больного приступают к внешнему осмотру очага поражения и лабораторным методам исследования. В некоторых случаях может потребоваться консультация инфекциониста, венеролога, иммунолога.
Чтобы подтвердить или опровергнуть предполагаемый диагноз, необходимо провести микроскопическое и бактериологическое исследование соскоба с очагов поражения на болезнетворные грибы. Для этого готовят мазок для микроскопии и делают высев исследуемого материала на селективную среду Сабуро. Инкубируют посевы в охлаждающем термостате при 22 градусах в течении 5 суток. На Сабуро растут кремовые или желтые колоний округлой формы и пушистой консистенции. При микроскопии обнаруживается септированный ветвящийся короткий мицелий и цепочки прямоугольных спор.
Осмотр под лампой Вуда поможет исключить другие заболевания с аналогичной клинической картиной.
Патогенез
Складки кожи — это места с повышенной влажностью и температурой и, а что создает условия для дерматофитов. Дерматофиты, попавшие в складки не вызывают проявлений заболевания, если сохранена барьерная функция кожных покровов, их кислотность и система специфической защиты организма.
Снижение этих факторов защиты, изменение биоценоза кожи способствует активному размножению гриба. Наличие повреждений рогового слоя вызывает повышение проницаемости кожи для патогенов. Возбудитель паховой эпидермофитии проникает в глубокие слои эпидермиса и в дерму и вызывает характерные высыпания.
Дерматофиты оказывают кератолитическое и липолитическое действие. Их фермент кератиназа разрушает только кератин человека. Рост и размножение грибов вызывает разрушение рогового слоя кожи. Характерно прогрессирование процесса, поэтому воспалительные изменения наиболее выражены на периферии очагов. Если скорость восстановления эпидермиса больше скорости размножения гриба, то часто возбудитель элиминируется и наступает самопроизвольное выздоровление.
Важная роль в патогенезе дерматофитий отводится эндогенным факторам. Паховая эпидермофития часто отмечается на фоне таких заболеваний, как сахарный диабет, гепатит, вегето-сосудистая дистония или при онкопатологии. Нередко проявления в складках служат «сигнальными признаками» сахарного диабета, поскольку бактерицидная активность кожных покровов у больных сахарным диабетом ниже, чем у здоровых. Также микозы крупных складок часто возникают при приеме системных глюкокортикостероидов при различных сопутствующих заболеваний (бронхиальная астма, ревматоидный артрит, красная волчанка). Очень тяжелое течение эпидермофитии кожи и складок отмечается у ВИЧ-инфицированных лиц.
Что это такое?
Возбудитель паховой эпидермофитии (код по МКБ-10 – В35.6) — Epidermophyton Floccosum. Попав в толщу эпидермиса, этот грибок активно размножается, создавая очаг воспаления. В исследуемых образцах пораженных тканей, как правило, присутствуют тонкие нити мицелия, а спор практически нет. Это говорит о том, что даже ничтожно малая «популяция» грибка разрастается очень быстро, стремительно увеличивая зону поражения.
Возбудителя эпидермофитии отличает также высокая контагиозность (так специалисты называют способность грибка передаваться от больного человека к здоровому). Среди заболевших, по медицинской статистике, больше мужчин, чем женщин. У ребенка паховая эпидермофития диагностируется крайне редко.
Случаи заражения стоп также не часты, но всё же иногда встречаются, поскольку инфицирование может происходить в спортивном зале, бассейне, где занимаются и дети, и взрослые.
Причины
Возбудители паховых микозов Epidermophyton floccosum (35-40% случаев), Trichophytom rubrum (15-20% случаев), Trichophytom mentagrophytes var. interdigitale (20-25%). Кандида и аспергиллы (условно–патогенные грибы) выявляются в ассоциации с вышеперечисленными. Таким образом, причиной поражений паховой области являются различные возбудители, а это значит, что для лечения необходимы противогрибковые препараты широкого спектра активности.
Паховой эпидермофитии способствуют повышенная температура воздуха, повышенная потливость и нарушение углеводного обмена. Не удивительно, что это заболевание имеет большую распространенность в местах с теплым и влажным климатом. Заражение происходит при контакте с больным, но чаще — через предметы (термометры, мочалки, белье), которыми пользовался больной.
В развитии эпидермофитии стоп имеет значение контакт с зараженными предметами в душевой, сауне, бассейне, жилых помещениях или ношение чужой обуви и носков. Отшелушившийся эпидермис у больных эпидермофитией или частички разрушенных ногтей попадают в окружающую среду в общественных местах, а затем на стопы здорового человека. Онихомикоз (поражение ногтей) преимущественно развивается при аутоинфицировании (от самого больного), если имеется длительное грибковое поражение кожи.
Предрасполагающими факторами микозов стоп и паховых складок являются:
- гипергидроз стоп;
- плохой гигиенический уход за ногами;
- неблагоприятные социальные условия;
- обменные и эндокринные нарушения, прежде всего сахарный диабет;
- высокая температура среды;
- травмы, опрелости, потертости;
- ношение тесной обуви;
- сниженная сопротивляемость организма;
- длительное применение антибиотиков, цитостатиков или кортикостероидов;
- ионизирующая радиация;
- хронические заболевания, сопровождающиеся иммунодефицитом (СПИД и прочие).
Причины возникновения
Заболевание является следствием недостаточного ухода за кожей, игнорирования средств личной гигиены. Болезнь заразна, инфицирование может произойти в общественном душе, бане, бассейне, если, например, здоровый человек воспользуется полотенцем, мылом, мочалкой человека больного.
Эпидермофития в паху возникает также при близком телесном контакте с заболевшим.
Серьезнее всего рискуют те, чей иммунитет ослаблен, а значит, не способен защитить человека от инфекции.
Кроме того, грибку помогают:
- высокая влажность в помещении;
- жара;
- склонность человека к активному потоотделению;
- избыточный вес, наличие жировых складок;
- различные, даже незначительные, травмы кожных покровов.
Симптомы
Клиническая картина эпидермофитии складок обусловлена разрушением рогового слоя кожи и выраженной воспалительной реакцией. Если патогенность дерматофитов усиливается, наступает обострение процесса и ухудшение общего состояния пациента. Очаги поражения отличаются способностью к периферическому росту. Связано это с тем, что скорость размножения патогена опережает защитную реакцию эпидермиса в виде пролиферации и восстановления.
Паховая эпидермофития у мужчин
У мужчин паховые складки поражаются чаще, нежели у женщин. Такая половая предрасположенность объясняется особенностями анатомии и физиологии мужского организма: более выраженная функция апокриновых желез генитальной области, отличающийся состав пота, выделяемого ими, и постоянная травматизация бедер при трении с мошонкой. Характерна симметричность поражения складок, поэтому имеется возможность скрытого течения процесса с другой стороны без клинических проявлений. Для предупреждения рецидива проводится профилактическое лечение внешне не измененной паховой складки.
Также имеется возможность скрытого течения микоза мошонки — она поражается постоянно, но клинические признаки невыраженные (легкая эритема). Дерматофитии паховых складок чаще встречаются у полных мужчин, с повышенной потливостью. Помимо поражения паховых складок у них могут поражаться подмышечные складки и под молочными железами.
Заболевание чаще всего начинается остро и, если не назначается правильное и своевременное лечение, возможен переход его в хроническую форму. Типичная локализация — кожа паховых складок и межъягодичные складки. Также возможен переход очагов на мошонку и член. Сначала появляется отечный ярко-красный очаг с шелушащейся кожей и периферическим валиком.
Фото паховой эпидермофитии у мужчин
Сформированный очаг содержит различные элементы: пятна, папулы, везикулы. Элементы сыпи отражают степень аллергической реакции на гриб: от наименьшей реакции — пятна, а при максимальной — везикулы в большом количестве, мокнутие и эрозии.
Для эпидермофитии характерен кольцевидный рост и расширение очага. По мере роста высыпания сливаются и формируют гирляндоподобные фигуры, которые распространяются далеко за пределы складок. Это происходит из-за того, что гриб внедряется в новые участки кожи и очаг выглядит расширяющимся кольцом. Больного беспокоит сильный зуд. В центре очага могут начинаться процессы разрешения, а по периферии по-прежнему происходит острый процесс. Полного разрешения пятен не происходит, но со временем покраснение сменяется бурым фоном.
Кожа мошонки поражается почти у всех пациентов и характеризуется небольшим покраснением. Эпидермофития нередко осложняется вторичной бактериальной и кандидозной инфекцией, особенно если применяются местные кортикостероидные мази в случаях неправильно поставленного диагноза. При неправильном лечении заболевание приобретает хронический характер с рецидивами.
Паховая эпидермофития у женщин
У женщин также поражаются складки, внутренняя поверхность бедра и низ живота. У женщин чаще отмечается поражение межъягодичной складки и ягодиц. Высыпания в виде очерченных, слегка возвышающихся округлых пятен розовато-коричневатого цвета, на поверхности которых имеется мелкопластинчатое шелушение. Характерен постепенный рост очагов и слияние близлежащих, поэтому они принимают фестончатые очертания. По периферии очага располагаются папулы. Зуд также, как и у мужчин является основным симптомом. Со временем центральная зона пятна бледнеет, а шелушение становится почти незаметным, воспаление в центре уменьшается. Этот процесс не касается периферии — здесь остается воспалительный валик (симптом шнура).
Фото паховой эпидермофитии у женщин
Возбудитель может поражать не только паховые складки, но и складки под грудью. Также в 19% случаев вовлекается кожа ягодиц и туловища. При этом очаги протекают с минимальными проявлениями: незначительное воспаление и шелушение. Их часто ошибочно диагностируют как лишай (розовый или отрубевидный) и поверхностную трихофитию.
Паховая эпидермофития: фото поражения ягодицы и ягодичной складки
Без лечения заболевание имеет длительный характер, с периодическими обострениями преимущественно в летнее время. При обострении вследствие потливости на поверхности очага снова появляются мелкие пузырьки, корочки, появляется зуд. Элементы сыпи появляются преимущественно на периферии очага. К такому же затяжному стертому характеру заболевания приводит использование кортикостероидных мазей, которые хорошо устраняют воспаление, но не действуют на возбудителя. У женщин осложнения возникают в 2 раза чаще, чем у мужчин. Преобладает пиодермия, на втором плане стоят аллергический дерматит и грибковая экзема. Лечение паховой эпидермофитии у женщин и мужчин будет рассмотрено ниже.
Эпидермофития стоп
E. floccosum поражает также стопы. Это хроническое грибковое заболевание, при котором поражается кожа и очень часто ногти. Эффективная местная терапия, на стадии поражения только кожи стопы, может предотвратить вовлечение в процесс ногтей. Поражение ногтевых пластинок протекает в виде дистально-латеральной формы, а ногтевые валики не вовлекаются.
Эпидермофития стоп протекает в различных формах: сквамозная, интертригинозная, дисгидротическая, сквамозно-гиперкератотическая, онихомикоз и острая форма. Среди клинических форм лидирует интертригинозная с поражением складок между III и IV пальцами. Реже встречается сквамозно-гиперкератотическая.
Сквамозная форма проявляется шелушением кожи (мелкое, отрубевидное) на своде стопы, подошве, в кожных бороздах. Иногда шелушение возникает на фоне покраснения. Процесс со временем распространяется на боковые поверхности пальцев.
При сквамозно-гиперкератотической форме на стопах образуются участки утолщения кожи как при омозолелости, а на нем — пластинчатое шелушение.
Интертригинозная форма начинается с шелушения кожи между пальцами стопы. Потом возникают опрелости, везикулы, которые вскрываются образуется трещина в складках, окруженная отслоившимся слоем эпидермиса. Между пальцами возникает зуд, иногда жжение.
При длительной ходьбе трещины углубляются и образуются в эрозии. При присоединении бактериальной или дрожжевой флоры появляется покраснение, отечность кожи, появляется боль и усиливается зуд. Течение данной формы хроническое, в летнее время отмечаются обострения.
При дисгидротической форме на сводах стопы, боковой поверхности снаружи, по краю подошвы, между пальцами появляются пузырьки с плотной покрышкой. Пузырьки заполнены прозрачным содержимым и выглядят как «саговые зерна». Пузырьки располагаются группами и часто сливаются с образованием многокамерных пузырей. После вскрытия пузырей образуются эрозии с валиком отслоившегося эпидермиса. Если присоединяется пиококковая флора, содержимое пузырей приобретает гнойный характер. У больных может развиться лимфангит (воспаление лимфатических сосудов) и лимфаденит (увеличение регионарных лимфоузлов). Это сопровождается повышением температуры, болью и общим недомоганием.
Фото эпидермофитии стоп дисгидротическая форма
Встречается дисгидротическая эпидермофития кистей и стоп одновременно. На ладонях отмечаются высыпания, которые называются эпидермофитиды. Но поражение кистей более характерно для рубромикоза, так как возбудитель Trichophyton rubrum обнаруживается при заболевании в 90% случаев.
Классическая форма проявляется покраснением и сухостью ладоней и подошв, муковидным шелушением в кожных бороздках. Рубромикоз стоп протекает как эпидермофития (сквамозная, дисгидротическая или интертригинозная), но отличается тем, что поражается не только подошва, но и тыльная сторона стопы. Здесь определяются бляшки с узелками, чешуйками, пузырьками, корочками. Такая же картина может быть и на кистях, но с меньшей интенсивностью. Руброфития кистей начинается с поражения ладоней и сочетается с онихомикозом. Наблюдается сухость кожи, утолщение, муковидное шелушение.
Очаги на тыле кисти появляются позже и представлены узелками, пузырьками и корочками. Инфицирование кистей происходит из очагов руброфитии на стопах при лимфогематогенном распространении грибов. Острая эпидермофития представляет собой обострения интертригинозной и дисгидротической форм. На фоне выраженного отека кожи появляются обильные везикулезно-буллезные элементы. Присоединяются пиодермических осложнений, лимфаденит, лимфангит, значительно повышается температура.
Онихомикоз (поражение ногтей) чаще 1-го, 4-го и 5-го пальцев стоп встречается в 25% случаев. У мужчин поражение ногтевых пластин встречается почти в 2 раза чаще, чем у женщин. Пораженные ногти утолщаются, а в толще пластины появляются желто-серые цвета пятна, под которыми образуется гиперкератоз, сама пластина разрыхляется и ломается. Развиваются разрыхление и ломкость значительно медленнее, чем при рубромикозе ногтей.
Стадии болезни
Болезнь при неблагоприятном развитии событий проходит ряд стадий:
- начальную,
- острую,
- запущенную,
- хроническую.
Если диагноз поставлен оперативно и вовремя начато лечение, последних двух можно избежать.
Начальная стадия характеризуется формированием очага инфекции в виде розовых пятен с папулами по краям.
Во время острой стадии размеры пятен увеличиваются, меняется их внешний вид: в середине воспаление исчезает, кожа сначала светлеет, а затем приобретает коричневатый оттенок. Появляются мокнущие участки. Больной испытывает зуд и дискомфорт во время ходьбы, а также при соприкосновении воспаленной кожи с одеждой.
Запущенная стадия наблюдается у тех больных, которые игнорируют лечение, не занимаются гигиеной – попадающие на кожу пыль и грязь усугубляют проблему. В это время может значительно расширяться зона поражения, болезнь захватывает стопы и даже ногтевые пластины.
Кроме того, возникает угроза присоединения к основному заболеванию какой-либо микробной инфекции. Стадия характеризуется появлением на коже волдырей, которые могут непроизвольно вскрываться, давая «зеленый свет» вирусам и грибкам. Если на этом этапе больной обращается за медицинской помощью, ситуацию можно взять под контроль — пациенту вскрывают пузыри, дезинфицируют ранки.
В хроническую стадию болезнь переходит обычно у тех пациентов, которые долго не обращались к врачу, занимаясь самолечением. У больных-хроников пятна сохраняются на коже, даже если болезнь на какое-то время отступила.
Воспаление обостряется при высокой температуре, влажности. Провоцируют вспышку эпидермофитии и «человеческие факторы» — нервное перенапряжение, стрессы, сильное потоотделение. Также от индивидуальных особенностей каждого организма, надежности его иммунной системы зависит то, насколько длительными будут ремиссии и как часто человек станет страдать от обострений.
Анализы и диагностика
- Микроскопия патологического материала используется как метод предварительной диагностики.
- Выделение культуры возбудителя (рост возбудителя в культуре) требует времени.
- Полимеразная цепная реакция (ПЦР). Дает возможность в течение суток получить результат, который является высокоспецифичным (90-98%). Особенно важен при онихомикозах и атипичных формах дерматомикозов, поскольку в самые ранние сроки позволяет назначить рациональную терапию, уменьшить осложнений и тяжесть поражений.
Epidermophyton floccosum — возбудитель паховой эпидермофитии
Грибы Epidermophyton flocosum являются антропофиллами. Они вызывают заболевание только у человека. Поражают чаще всего поверхностный слой гладкой кожи: чаще паховых складок, реже межъягодичных, складок внизу живота и под молочными железами.
При микроскопии чешуек кожных покровов, взятых из пораженных участков, обнаруживается короткий (2 — 4 мкм) разветвляющийся переплетенный мицелий и прямоугольной формы артроспоры, располагающиеся цепочками. При росте на питательной среде Сабуро колонии округлой формы, вначале плоские или куполообразные, позднее складчато-бугристые с углублениями в центре. Поверхность бархатисто-мучнистая или кожистая с радиальной складчатостью. Вначале серовато-коричневого, лимонно-оливкового или желтовато-зеленого цвета, позднее — белые.
При микроскопии в зрелых культурах можно видеть септированный мицелий с тупоконечными макроконидиями, которые располагаются в виде дубинок или гроздьев бананов пучками по 3 — 5 штук, растут прямо из гиф. Хламидоспоры появляются у старых культурах. Микроконидии отсутствуют.
Рис. 3. Вид колоний грибов Epidermophyton flocosum на разных стадиях роста.
Рис. 4. Микроскопия зрелых культур грибов Epidermophyton flocosum.
Процедуры и операции
При запущенной форме онихомикоза и необратимых изменениях ногтевой пластины пациенту может быть предложено хирургическое удаление ногтевой пластины, которое проводится под местной анестезией. После операции на рану наносится мазь с антибиотиком и противогрибковым препаратом. Повязка меняется два раза в день. Курс лечения местными противогрибковыми средствами продолжается до отрастания здорового ногтя — на это может уйти 6-9 месяцев.
Также используется лазерное удаление пластины ногтя. Процедура менее болезненна и бескровная, чем обычное хирургическое удаление ногтя, отличается быстрым восстановлением тканей, а деформации отрастающего ногтя отсутствуют. Если ногтевая пластина поражена незначительно, полностью ее с применением лазера не удаляют. Достаточно разрушить лазерным воздействием мицелий и споры патогена. С помощью лазера это возможно, поскольку он проникает через ноготь в мягкие ткани на 7-8 мм. Курс лечения составляет 4-5 процедур, а через месяц рекомендуется повторить курс лечения.
Как лечить паховую эпидермофитию у мужчин и женщин
При комплексном подходе к лечению, включающем в себя медикаментозную и физиотерапию, диету и народные средства, удается быстро справиться с симптомами болезни и снизить риск ее распространения.
Медикаментозное лечение
Против зуда кожи больным помогают такие антигистаминные препараты, как Зиртек, Супрастин.
Наиболее эффективными мазями для лечения данной грибковой инфекции специалисты считают:
- Микозолон (быстро устраняет зуд);
- Тридерм (разрушающе действует на грибок, используется в течение 1 месяца, наносится на воспаленные участки кожи 2 раза в день);
- Клотримазол (безопасен для слизистых, курс лечения – 1 месяц);
- Ламизил (используется 1-2 раза в сутки);
- Тербинафин (наносится на кожу 1-2 раза в день, может использоваться в течение 0,5 месяца).
Из таблетированных препаратов рекомендуются:
- Гризеофульвин,
- Итраконазол,
- Флуконазол.
Если заболевание протекает тяжело, с осложнениями, могут быть назначены антибиотики – Диклоксациллин, Миноциклин. Курс этого лечения может длиться 5-14 дней.
Больному потребуются также дезинфицирующие растворы (например, хлорида серебра).
Физиотерапия
Для снятия болезненных симптомов врач может назначать пациенту лечение ультрафиолетовыми лучами. Оно снимает отечность, останавливает развитие заболевания, поддерживает защитные силы организма.
При данном диагнозе эффективны также магнитная терапия и озонотерапия.
Узнать о том, как начинается стрептодермия у взрослых и как ее следует лечить можно по ссылке.
О симптомах и лечении нейродермита у взрослых читайте в данной статье.
Ответ на вопрос: «Что такое сучье вымя?» найдете тут.
Народные средства
Эти средства не смогут полностью вылечить эпидермофитию, но, как правило, полезны для укрепления иммунной системы больного, снижения неприятных симптомов воспаления. Лечение этими средствами требует согласования с врачом.
Вот что можно использовать наиболее эффективно:
- Мази с эфирными маслами. Главным ингредиентом лучше всего сделать льняное масло, добавив к нему по 1 капле нескольких эфирных (например, гвоздики, инжира). Средство агрессивно воздействует на грибок, избавляет больного от неприятного зуда. Использовать мазь нужно ежедневно.
- Лосьон из оливкового масла и сока чистотела (в соотношении 3:1). Такая концентрация сока делает его безопасным для обработки мест воспалений. Если же использовать сок в чистом виде, велик риск ожога кожи. Обработку лосьоном желательно проводить по несколько раз в день, в крайнем случае — 1 раз, в вечернее время.
- Березовая настойка. Ее готовят из свежих листьев – промывают водой и настаивают на спирту в течение недели. Важно, чтобы растительное сырье было полностью закрыто жидкостью. Готовой настойкой смачивают ватные диски и обрабатывают воспаленные участки кожи.
- Семена черной редьки. Их заливают горячей водой и настаивают в течение 5 часов. Готовое средство по своей консистенции должно напоминать сметану. Им, как кремом, смазывают больные участки кожи дважды в сутки.
- Дикий чеснок. Измельчив это растение до состояния кашицы, из него готовят компресс. Прикладывают его к больным участкам кожи в паховой области.
- Ванны с базиликом. 100 г этого растения и такое же количество лиственника заливают водой, кипятят и настаивают. Добавляют в ванну, которую принимают 20 мин. Чтобы лечебный эффект был ощутимым, надо принять 12 таких процедур.
- Мазь с фиалкой. Если с инфицированного участка кожи требуется снять струпья, в растительное масло добавляют цветки фиалки, вербену и буру, настаивают в течение 0,5 месяца, а затем кипятят и процеживают.
Диета
Для скорейшего выздоровления больному необходимо пересмотреть свое меню. Диета предполагает отказ от жирных кушаний, грибов, хлеба и выпечки из муки высшего сорта. До минимума нужно свести употребление сахара и сладостей.
Полезными для больного эпидермофитией являются кефир, йогурт, чеснок, шпинат, хрен, орехи, цитрусовые фрукты. Хлеб надо выбирать цельнозерновой либо испеченный из муки 2-го сорта.
Профилактика
Важно соблюдение правил личной гигиены:
- Ежедневное мытье ног прохладной водой с хозяйственным мылом.
- Ежедневная смена носков.
- Ношение обуви по сезону, поскольку чрезмерно теплая обувь может спровоцировать сквамозную эпидермофитию.
- В общественных местах (баня, сауна, бассейн) обязательно пользоваться индивидуальной резиновой обувью.
- Иметь в личном пользовании отдельное полотенце для ног и тела и индивидуальные ножницы.
- Не допустимо использование чужой обуви в повседневной жизни.
- Активное лечение потливости.
- Дезинфекция обуви для недопущения реинфекции и рецидива. Для снижения вероятности рецидива нужно обработать всю обувь больного раствором формальдегида.
- Своевременное лечение общего заболевания, которое провоцирует кожную патологию.
В общественных местах:
- Проведение частой дезинфекции полов, скамеек, настилов, душевых, бассейнов.
- Осмотр работников бань, саун и бассейнов на выявление эпидермофитии.
- Регулярные осмотры посещающих бассейны дерматологом.
Профилактические процедуры
Заражения эпидермофитией, а также рецидивов заболевания можно избежать, если:
- строго придерживаться общепринятых гигиенических норм;
- регулярно промывать складки в паху, в районе гениталий;
- вытираться исключительно своими полотенцами, не брать чужих мочалок, мыла во время посещения бани, душевой;
- брать с собой в бассейн, спортзал специальную обувь, не ходить там босиком;
- после водных процедур насухо вытирать ноги (особенно кожу между пальцами), использовать средства против усиленного потоотделения;
- отдавать предпочтение белью и одежде из натуральных волокон, особенно в жаркие месяцы;
- беречь нервную систему, поскольку стрессы вызывают обострение заболевания;
- при подозрении на инфицирование посещать дерматолога.
В качестве профилактики заболевания можно также рассматривать употребление витаминных препаратов и укрепляющую иммунитет терапию. Необходимые назначения делает лечащий врач.
Напоследок рекомендуем также посмотреть следующее видео о лечении эпидермофитии:
Последствия и осложнения
При эпидермофитии стоп осложнениями считаются:
- Переход из одной формы в другую.
- Онихомикоз.
- Присоединение бактериальной инфекции — вторичная пиодермия, лимфангит, лимфаденит и рецидивирующее рожистое воспаление, резистентное к лечению антибиотиками. На фоне таких поражений возникает тромбофлебит, лимфостаз и слоновость (элефантиаз).
- Аллергизация организма: крапивница, бронхиальная астма, аллергический ринит, возникновение микидов. Это вторичные аллергические высыпания при микозах.
При паховой эпидермофитии:
- Микотическая экзема. Она встречается при хронической форме, проявляется лихенизацией кожи (уплотнение), которое возникает от расчёсов. Процесс напоминает нейродермит.
- Аллергический дерматит.
- Импетигинизация — развитие импетиго, как осложнения микоза. Импетиго — это стрепто-стафилококковое поражение кожи.
Осложнения: чем опасно заболевание
Главная опасность эпидермофитии – ее затяжной характер в случае несвоевременно начатого лечения. Возможные осложнения:
- атрофия участков кожи;
- отеки;
- болезненные ощущения при совершении полового акта;
- мигрени;
- вторичное инфицирование микробами и грибками;
- лимфаденит и лимфангит.
Информацию о симптомах, лечении, фото дерматомикоза ищите в этой публикации.
С перечнем вытягивающих мазей от фурункулов можно ознакомиться по ссылке:
Прогноз
Несмотря на то, что для эпидермофитии характерно длительное течение и склонность к рецидивированию, прогноз относительно обычно благоприятный. Если правильно назначено лечение наступает выздоровление. При этом важно тщательно соблюдать сроки лечения, соблюдать правила личной гигиены и устранить все факторы риска, в том числе корректировать уровень сахара при сахарном диабете.
Эпидермофития стоп характеризуется более упорным течением, но при правильном и длительном лечении прогноз относительно выздоровления также благоприятный. При присоединении бактериальных инфекций прогноз заболевания более серьезный. Онихомикозы поддаются лечению, однако оно должно быть длительным и с применением системных препаратов. Эффект при лечении онихомикоза зависит не только от распространенности процесса, формы поражения ногтя и правильного выбора средств, но и от проведения дезинфекции обуви вплоть до отрастания здорового ногтя.
Паховый грибок — другие причины
Причиной пахового микоза кроме Epidermophyton floccosum (паховая эпидермофития) являются грибы Trichophyton rubrum (руброфития), Malassezia furfur (отрубевидный лишай) и Candida albicans (кандидоз).
Паховый грибок, вызванный Trichophyton rubrum (паховая руброфития)
Руброфития является наиболее часто встречающейся грибковой инфекцией. Грибы Trichophyton rubrum поражают стопы, кисти рук, ногти и гладкую кожу, в том числе пахово-бедренные складки, голени и ягодицы. Эпидемиология и распространение заболевания сходна с таковой при паховой эпидермофитии.
После инфицирования в паху появляются овальной или округлой формы гиперемированные очаги с шелушением, по периферии которых располагается прерывистый воспалительный валик вишнево-красного цвета. На его поверхности располагаются папулы, везикулы и пустулы. Зона воспаления имеет четкие границы. Отмечается склонность к периферическому росту. Сливаясь, участки воспаления приобретают полициклические очертания. Расположение ассиметричное, часто в складках под животом и на бедрах. Болезнь сопровождается сильным зудом. Разрешение очагов происходит с центра, где кожные покровы бледнеют и приобретают бурую, желтоватую или синюшную окраску. Постоянные расчесы приводят к травмированию кожных покровов. В пораженных зонах появляются геморрагические корочки и формируются участки лихенизации.
Паховую руброфитию следует отличать от паховой эпидермофитии, красной волчанки и токсикодермии.
Рис. 7. На фото возбудитель пахового грибка Trichophyton rubrum: рост колонии (фото слева) и микроскопическая картина чистой культуры (фото справа).
Рис. 8. Паховая руброфития у мужчины и женщины.
Паховый грибок, вызванный Malassezia furfur
Отрубевидный лишай является довольно распространенным микозом. Болезнь чаще встречается у лиц молодого возраста. Грибы Malassezia furfur паразитируют в самых верхних слоях кожного покрова и в зонах волосяных фолликулов. При определенных условиях они способны вызвать заболевание. Считается, что причиной отрубевидного лишая является изменение химического состава пота при повышенной потливости. Патология желудочно-кишечного тракта, эндокринной системы, нейровегетативная патология и иммунодефицитные состояния являются пусковым механизмом развития микоза.
Очаги поражения локализуются, в основном, на коже груди и живота, значительно реже — на кожных покровах головы, конечностей и паховых областей.
При заболевании в области паха появляются пятна розовой окраски, поверхность которых незначительно шелушиться. Пятна склонны к слиянию. Их цвет со временем меняется на светло- или темно-коричневый. Течение микоза длительное, рецидивирующее.
В лучах лампы Вуда, дающей люминесцентное свечение, пораженный участок дает желтоватое свечение, а проба с йодом дает положительный результат.
Рис. 9. Возбудители пахового грибка Malassezia furfur под микроскопом (фото слева). Рост колоний (фото справа).
Рис. 10. Вид участков поражения грибами при отрубевидном лишае (фото слева). Паховый грибок у мужчины (фото справа).
Паховый грибок, вызванный Candida albicans
Виновником кандидоза являются дрожжеподобные грибы рода Candida albicans, широко распространенные во внешней среде. Они постоянно, начиная с момента рождения, паразитируют на кожных покровах и слизистых оболочках, не вызывая заболевания. Резкое снижение иммунитета и назначение длительных курсов антибиотиков служат пусковым механизмом развития микоза. Кандидоз развивается в случае одномоментного попадания на кожные покровы большого количества возбудителей. При некоторых профессиях возбудители попадают к человеку постоянно малыми порциями. Болезнь нередко регистрируется грудных детей. В группе риска по заболеванию находятся больные сахарным диабетом и тяжелой соматической патологией. Болезнь поражает больных с иммунодефицитом и нейровегетативными нарушениями.
При кандидозе изменения прежде всего локализуются в крупных и мелких складках тела человека. При распространенной форме микоза участки воспаления распространяются на кожу туловища. Заболевание протекает длительно. Часто рецидивирует.
Вначале пораженные участки приобретают красный цвет, на фоне которого видны множественные мелкие пузырьки (везикулы). Процесс распространяется очень быстро. Красный цвет меняется на насыщенно красный. На месте везикул появляются участки эрозии. Границы очага четкие. По периферии возникают множественные очаги отсева.
Грибы Candida albicans выделяют фермент, расщепляющий кератин, в результате чего в глубине складок скапливается кашицеобразная масса белого цвета отслоившегося рогового слоя эпидермиса. Он же виден невооруженным глазом по краю очагов в виде белой бахромки. При распространении заболевания появляются свежие пузырьки и пустулы.
Рис. 11. На фото грибы Candida albicans — возбудитель пахового микоза: вид под микроскопом (фото слева) и выпуклая, шарообразная колония возбудителей белого цвета, сметанообразной консистенции (фото справа).
Рис. 12. На фото типичная картина воспаления в паху при кандидозе.
Рис. 13. Грибок в паху у женщин при кандидозе.
Рис. 14. Грибок в паху у мужчин. Причина — грибы Candida albicans.
Список источников
- Сергеев А. Ю., Сергеев Ю. В. Грибковые инфекции (руководство для врачей). М., 2003. 185–193.
- Лещенко В. М. Грибковые заболевания кожи. В кн.: Кожные и венерические болезни (руководство для врачей). Под ред. Ю. К. Скрипкина, В. Н. Мордовцева. М., 1999. Т. 1. С. 257–311.
- Сергеев В.Ю., Сергеев А.Ю. Дерматофии: новое в диагностике, терапии и профилактикенаиболее распространенных микозов человека. Consilium medicum.– Дерматология.–2008.–№1.–С.30–35.
- Халдин А.А.,Сергеев В.Ю., Изюмова И.М. Современные представления о паховых дерматофитиях: этиология, эпидемиология, клиника и эффективная терапия. Рос.журн. кож. и вен. бол.– 2005.–№ 5.–С. 43–48.
Эпидемиология паховой эпидермофитии
Грибы Epidermophyton floccosum распространены повсеместно. Среди всех грибковых заболеваний паховая эпидермофития составляет не более 1,2 — 1,8%. Чаще болеют мужчины, дети — редко, случаи микоза у них регистрируются в период полового созревания.
Контагиозность (заразность) паховой эпидермофитии довольно высокая. Встречаются вспышки заболевания в домах престарелых, больницах, школах и семьях. Заражение происходит в саунах, банях, душевых и уборных, при пользовании общей ванной, через мочалки, полотенца, губки, белье больного человека, клеенки, термометры и подкладные судна, в спортзалах через инвентарь.
Способствуют развитию паховой эпидермофитии:
- повышенная потливость,
- ожирение,
- ношение тесной и теплой (не по сезону) одежды,
- пребывание в условиях влажного климата,
- длительный прием глюкокортикоидов.
- мацерация кожных покровов,
- согревающие компрессы.
Рис. 2. Грибок в паху у мужчины.
Стадии заболевания
Развитие эпидермофитии происходит в несколько этапов:
- Скрытый или инкубационный этап. После 2–3 недель, прошедших от момента заражения, появляются первые видимые симптомы.
- Период проявления активных признаков заболевания. Интенсивность клинических симптомов может быть различна и продолжаться от недели до 2–3 месяцев.
Дальнейшее развитие заболевания зависит от самого больного:
- своевременное начало лечения лекарственными препаратами;
- в случае отсутствия терапии переход в хроническую форму с последующими частыми рецидивами;
- самопроизвольное исцеление, которое происходит очень редко;
- заболевший, у которого нет выраженных симптомов, становится носителем инфекции, в этом случае он представляет эпидемиологическую опасность.
Без соответствующего лечения инфекция обостряется в летний период или при нахождении в районе с влажным климатом.
Введение
Эпидермофития стоп — инфекционное заболевание, возбудителям которого являются почвенные грибы (сапрофиты).
Имеет широкое географическое распространение, поражает абсолютно все слои населения, однако отдельные группы людей страдают от данного вида грибковой инфекции чаще других. Так, на долю работников горячих цехов, спортсменов, шахтеров и других людей имеющих подобные профессий приходится от 60-ти до 80-ти процентов случаев заболевания. При этом в городах население болеет эпидермофитией значительно чаще, чем в сельской местности, а дети заболевают намного реже взрослых.
Поражение кожи в паху негрибковой природы
Кроме грибов кожа в паху поражается при эритразме, опрелости (интертриго) и пузырчатке. Очень редко поражается паховая область и половые органы при псориазе.
Интертриго (опрелость)
Механические дерматиты или опрелости возникают в результате трения, давления, воздействия тепла и других факторов, появляются во всех складках человеческого тела, но чаще всего в нижней части живота у полных людей, области ягодиц и половых органов.
В процесс вовлекаются верхние слои эпидермиса. Кожные покровы повреждаются продуктами кожной секреции, что проявляется разлитым покраснением с участками мацерации, образованием пузырей и трещин. Очаги не имеют четких границ. Больных беспокоит боль и зуд. Опрелость может осложняться бактериальной и грибковой инфекцией, о чем свидетельствует появление на участках воспаления мелких пузырьков. На первой стадии заболевания появляется покраснение, далее на фоне гиперемии возникают эрозии, без лечения кожные покровы приобретают ярко-красную окраску, эрозии сливаясь, образуют обширные очаги повреждения, на которых появляются язвы.
Рис. 15. На фото опрелость у мужчин.
Рис. 16. На фото опрелость у женщин.
Рис. 17. На фото интертриго у мужчин на половом органе и вокруг ануса.
Интертриго (опрелость) псевдомонадная
Обычная опрелость, осложненная бактериальной инфекцией Pseudomonas aeruginosa (синегнойная палочка) носит название псевдомонадой интертриго. Псевдомонады паразитируют на коже человека и при определенных обстоятельствах способны вызвать поражение кожных покровов. Пусковым механизмам может служить повышенная потливость, ожирение, некачественная и неудобная одежда, аллергическая настроенность организма, недостаточный уход за своим телом и др.
Участки воспаления неправильной формы темно-красного цвета. На них возникает множество мелких пузырьков, наполненных гнойным содержимым. Они быстро вскрываются, образуя эрозии, которые далее покрываются корочками. Постепенно площадь поражения увеличивается.
Рис. 18. Колонии бактерий Pseudomonas aeruginosa.
Рис. 19. Псевдомонадная опрелость у мужчин. Поражена паховая область и половой член.
Рис. 20. Интертриго псевдомонадная у мужчины.
Эритразма
Бактериальное заболевание кожи, вызываемое Corynebactcrium minutissimum, называется эритразмой. Способствует ее развитию повышенная потливость, ожирение и частое мытье с мылом, что ослабляет «кислотную мантию» кожных покровов, повышенная температура окружающей среды и влажность. При заболевании поражается роговой слой эпидермиса. Очаги воспаления локализуются, в основном, в области бедер, мошонки, подмышек и под молочными железами.
Эритразма имеет вид пятен красно-коричневого цвета с неровными краями, легким шелушением и резкими границами. Зуд незначительный. При повышенной потливости пятна приобретают красный цвет, возникает отечность и появляются пузырьки. В лучах лампы Вуда очаги воспаления светятся кораллово-красным свечением.
Рис. 21. Эритразма паховой области у мужчины и женщины.
Рис. 22. Эритразма пахово-бедренной складки и бедер у мужчин.
Рис. 23. Вид участка воспаления при эритразме в лучах лампы Вуда.
Псориаз
Заболевание с невыясненной природой возникновения и развитием патологического процесса. Очень редко поражается паховая область и половые органы, где появляется отечность и ярко-красного цвета бляшки.
Рис. 24. Псориаз половых органов.
Пузырчатка
Заболевание с невыясненной природой возникновения и развития патологического процесса. Предполагается, что пузырчатка является аутоиммунным заболеванием. В организме больного вырабатываются антитела преимущественно IgG к цементирующей межклеточной субстанции эпидермиса. Аутоиммунные процессы, происходящие в организме, приводят к разрушению шиповатого слоя эпидермиса.
При локализации процесса в области паха отмечается возникновение кратковременно существующих пузырей. После их исчезновения остаются обширные болезненные эрозии и обрывки эпителия.
Рис. 25. На фото слева пузырчатка у мужчины (буллезный пемфигоид). На фото справа хроническая доброкачественная семейная пузырчатка Хейли-Хейли.
Уход за стопами
Стопы следует поддерживать в сухом и чистом состоянии, для этого нужно:
- высушивать кожу между пальцами после приема ванны или плаванья;
- носить носки дома;
- ходить в обуви, которая позволяет дышать стопе;
- носить хлопчатобумажные носки, впитывающие влагу, и менять их дважды в день;
- наносить на стопы противогрибковую присыпку или тальк;
- ходить в шлепанцах в общественных бассейнах, банях и тому подобных местах.
При наличии эпидермофитии стоп после приема ванны или душа сначала следует высушивать область паха, а только потом ноги. Также в первую очередь необходимо надевать носки, а затем уже нижнее белье. Такие действия позволят предотвратить дальнейшее распространение грибковой инфекции со стоп в паховую зону, что может повлечь паховую эпидермофитию.
Некоторые люди не занимаются лечением рассматриваемой патологии, поскольку у них нет сильно выраженных симптомов. Однако следует помнить, что невылеченная эпидермофития способна привести к появлению трещин и волдырей, а это уже чревато присоединением тяжелой бактериальной инфекции. Помимо этого, если вы не лечите болезнь, то можете заражать ей других людей.
Признаки и фото
Симптомы паховой эпидермофитии у мужчин следующие:
- розовые шелушащиеся пятна (диаметр обычно около 1 см);
- их границы окрашены в ярко-красный цвет;
- со временем пятна захватывают все большую площадь, они могут затрагивать область бедер, паха, а также мошонку с анусом;
- по мере течения болезни центр пятен бледнеет, а на их границах образуются мокнущие валики;
- ближе к границам пятен могут образовываться пузырьки, корки и чешуйки;
- пораженные места сильно зудят, больной ощущает жжение и скованность в движениях.
Обострением заболевания считается период от образования первых маленьких пятнышек и до их разрешения, когда начинают формироваться крупные бледные пятна, окруженные валиком. Затем наступает период ремиссии.
Обострения и ремиссии могут чередоваться в течение продолжительного времени (месяца и даже года). Чаще всего болезнь дает о себе знать летом, а также когда человек сталкивается с сильным потоотделением.
Если вы обнаружили у себя перечисленные признаки, немедленно обратитесь к врачу. Болезнь всегда легче вылечить на ранней стадии, не затягивайте.
Фото паховой эпидермофитии у мужчин:
Профилактика заболевания
Профилактические меры сводятся к устранению факторов, приводящих к инфицированию, поддержанию личной гигиены, восстановлению защитных свойств иммунной системы.
Факторы, способствующие заболеванию:
- чрезмерное потоотделение;
- специфика рабочих условий;
- активный образ жизни;
- тяжёлый физический труд;
- посещение общественных душевых, саун, бассейнов, бань;
- пренебрежение личной гигиеной;
- близкий контакт с заражёнными людьми.
При активном образе жизни или физической нагрузке, стоит уделять больше внимания личной гигиене, не использовать чужие предметы личного использования – полотенца, тапочки, нижнее белье.
Медикаментозная терапия
Паховая эпидермофития у женщин, лечение которой производится по той же схеме, что и при грибковых заболеваниях гладкой кожи, требует комплексного подхода. С целью профилактики повторных рецидивов необходима одновременная терапия других очагов микоза и обработка кожи в тех областях, где инфекция существовала ранее.
Основу лечения составляют местные и системные противогрибковые средства. В запущенных случаях назначают комплексные мази с содержанием фунгицидного компонента и глюкокортикостероидов, оказывающих противозудное и успокаивающее действие.
Системная терапия показана в следующих случаях:
- неэффективность местного лечения;
- наличие воспалительной реакции на участках, отдаленных от грибкового очага;
- большая площадь поражения;
- островоспалительный процесс;
- сочетание с микозом стоп и ногтей.
В качестве лекарственных средств, применяемых в системной терапии, назначают препараты, указанные в таблице ниже.
| Название | Активный компонент | Дозировка/длительность курса для взрослых | Средняя цена, руб. |
| Итраконазол | Итраконазол | 200 мг 2 раза в сут./2 нед. | 240 руб./15 шт. по 100 мг |
| Флуконазол | Флуконазол | 300 мг 1 раз в нед./2 нед. | 80 руб./4 шт. по 150 мг |
| Тербинафин | Тербинафин | 250 мг 1 раз в сут./2-4 нед. | 120 руб./10 шт. |
Во время грибковых заболеваний у пациентов часто снижается общий иммунитет.
Поэтому для его укрепления врач может назначить легкие иммуностимуляторы (Иммунал, Ликопид, Имунорикс и другие). В случае, если присоединяется вторичная бактериальная инфекция, то проводится лечение антибактериальными препаратами. При обширном поражении кожного покрова терапия производится в условиях стационара.
Первый этап
Для лечения данного заболевания в острой фазе применяют примочки или влажные повязки, пропитанные растворами следующих веществ:
- 0,25% раствор нитрата серебра. Этот препарат отсутствует в свободной продаже. Его приготавливают и применяют непосредственно в лечебном учреждении.
- 1-2% раствор борной кислоты;
- 1-2% раствор резорцина;
- 0,05% раствор хлоргексидина биглюконата.
Вместо них в домашних условиях можно использовать мази с антимикотическим действием:
- Тридерм;
- Травоген;
- Микоспор;
- Клотримазол-акрихин и другие.
Для устранения зуда и жжения назначают антигистаминные лекарства (внутрь):
- Диазолин;
- Зиртек;
- Цетрин;
- Зодак и другие.
Второй этап лечения
Паховая эпидермофития у женщин на втором этапе терапии купируется при помощи препаратов в форме крема или геля. Содержание активного вещества в них меньше, чем в мазях.
Лечение проводится с использованием следующих средств:
- Батрафен;
- Кандид;
- Ламизил;
- Экодакс;
- Экзифин и другие.
После того, как разрешаются пузырьки, заживают язвочки и трещины, применяют 2% раствор йода, салициловый спирт, Фукорцин или серно-дегтярную мазь. Наносить их на кожу с открытыми ранами нельзя, так как это может вызвать воспаление или химический ожог.
Общая продолжительность наружного лечения составляет в среднем 2-4 недели. Для профилактики повторного возникновения микоза обработку поверхности кожи проводят также в течение 1-2 недель после исчезновения симптомов. Кремы, мази и гели наносят непосредственно на пораженную область, захватывая участки на 2-3 см вокруг нее.
Что такое эпидермофития стоп
Эпидермофития стоп – дерматоз кожи, спровоцированный заражением грибами рода Эпидермофитон. Заражение патогенными грибами происходит при тесном контакте с носителем или вещами, которые ним использовались.
Чаще всего инфицирование случается в общественных банях, на пляжах и в бассейнах. Опасность эпидермофитии стоп заключается в том, что это заболевание сложно поддается лечению.
Возбудитель инфекции может жить в организме человека годами и никак не проявлять себя. Выраженный патологический процесс наблюдается в случае снижения иммунитета.
Лечение
Терапия заболевания – комплекс индивидуально подобранных мер, нацеленных на устранение инфекции, симптомов и причин. Микология предлагает несколько методик лечения заболевания, которые комбинируются или используются самостоятельно.
Рассмотрим, как лечить заболевание:
- На начальном этапе терапия нацелена на устранение воспалительного процесса и механическое удаление пораженных участков кожи. Используется спиртовой раствор салициловой кислоты. При мокнущих язвах используется салицилово-цинковая паста.
- Для приема внутрь назначаются антигистаминные препараты, блокирующие воспалительный процесс. Дополнительно применяются препараты для стимуляции иммунитета.
- Показано наружное применение противогрибковых средств и регулярная обработка кожи стоп антисептическими растворами для профилактики вторичного инфицирования.
- Рецидивирующие формы заболевания требуют дополнения терапевтического комплекса аутогемотерапией и витаминами группы В.
Хирургическое вмешательство показано только в случае инфицирования ногтей. Ногтевая пластина удаляется после устранения грибковой инфекции и на ее месте вырастает здоровый ноготь.
Последствия
Осложнения являются результатом неэффективной терапии или же слабой иммунной реакции. Если вовремя не начать лечение, могут возникнуть следующие последствия:
- поражение лимфатической системы,
- генерализация,
- присоединение бактериальной инфекции,
- абсцессы.
Народная медицина
Заниматься домашней диагностикой по фото в интернете и самостоятельно лечиться – опасно. Наука не располагает данными об эффективности народной медицины. Поэтому, лечение народными средствами допустимо только как дополнение медикаментозной терапии.
Безопасными средствами являются лечебные ванночки из настоя следующих трав:
- ромашка аптечная;
- чистотел;
- зверобой.
Формы заболевания и их симптомы
Эпидермофитию делят на клинические формы заболевания, характеризующие место локализации и особенности проявления:
- сквамозная форма;
- интертригинозная;
- дисгидротическая;
- эпидермофития ногтей.
Сквамозная форма
Самая опасная форма грибка, так как симптомы ненавязчивы и не вызывают беспокойства. Шелушение стоп, покраснение у их свода, редкий слабый зуд. Врачи же отмечают, что пациентам свойственно с годами соседствовать с этой формой, быть переносчиком микоза из-за собственного невнимания к здоровью. Дисгидротической и сквамозной эпидермофитии свойственно перетекать в обеих формах попеременно.
Сквамозная форма — наиболее опасная разновидность грибка
Интертригинозная форма
Развивается на фоне нелеченной сквозной эпидермофитии. Зуд и шелушение рассеивается на межпальцевую зону, сгибы пальцев ног. Особенно страдают мизинец и безымянный пальцы. Образуются мокнущие раны, эрозии и трещины. Характерна отслойка белесых корок эпидермиса.
Обострение приходится на лето, зимой заболевание малоактивно.
Интертригинозная форма грибка поражает межпальцевую зону ног
Кожа становится рыхлой, тресканой и слабой по отношению к инфекциям. Характерно для запущенной формы. К примеру, стрептококк в сочетании с эпидермофитией опасен рожей голени или тромбофлебитами.
Дисгидротическая форма
На подошве стопы образуются скопления пузырьков небольших размеров. Со временем они соединяются в единую площадь. Стопа становится болезненной. Снятие верхнего слоя – значит открыть язвы и эрозии. Пузыристый слой поднимается на бока стопы. Когда кожа зажила, а пузырчатость ушла, считается, что вернулась сквамозная форма.
Обостряется весной и летом. Сопровождается повышенной температурой тела и недомоганием, возможны высыпания по типу аллергии. Острая форма держится 1-2 месяца, но своевременная терапия в такие этапы эффективна, как никогда.
Дисгидротическая форма грибка характеризуется появлением небольших пузырьков на коже
Также опасно вторичным инфицированием. Жидкость в волдырях становится мутного, белесого цвета – это нагноения. Так развивается лимфаденит, лимфангит.
Стёртая форма
Кроме скромной площади шелушения ног и редких трещин между пальцев, нет никаких симптомов. Эти признаки также редко выдают присутствие болезни. Пациенты рассуждают, что это такое раздражение или авитаминоз.
Стертая форма встречается на начальных этапах заболевания и перетекает в другую.
При стёртой форме грибка стопы образуется шелушение и трещины между пальцами
Эпидермофития ногтей
Поражает сугубо ногтевую пластину. В преимуществе большие пальцы ног и мизинцы. Ноготь становиться жёлтым, видны откровенные полосы, расслоения и утолщения. Пластина крошится, ломается или самостоятельно отстает от пальца, как на фото.
Эпидермофития ногтей чаще поражает мизинцы и большие пальцы ног
Руки вне опасности. Это не повод пользоваться одним маникюрным набором для ног и рук. Заведите отдельные инструменты для больного и здоровых ногтей. После лечения избавьтесь от зараженных.
Сквамозная эпидермофития
Сквамозная эпидермофития стоп проявляется в виде бляшек красного цвета с серовато-белым шелушением или плоских папул, которые появляются на кожных покровах свода или на боковых частях стопы. Очаги поражения могут напоминать типичные для псориаза бляшки и иметь четкие границы. По окружности бляшек находится бордюр, состоящий из отслаивающейся кожи единичными маленькими пузырьками. Часто шелушения сочетаются с явлениями подошвенного гиперкератоза в виде трещинок и омозолелостей желтого оттенка на поверхности, которые напоминают проявления механического дерматита. Характерны непостоянные и умеренные зудящие ощущения.
Современные методы диагностики
Предположить будущий диагноз помогает совокупность симптомов, исследование тканей при помощи микроскопа. Для анализа у пациента берут отслоившиеся слои покровов, на некоторое время замачивают в щелочи. Под воздействием агрессивного вещества удается увидеть нити грибков. Чтобы изучить стадию заболевания потребуется дополнительно изучить частички.
При дисгидротической и интертригинозной форме заболевания материал для анализа забирают по периферии очагов, где имеется отслаивающийся эпидермис. При сквамозной форме с очага инфекции соскабливают чешуйки.
При патологии ногтей с них при помощи скальпеля соскабливают роговые массы, можно также срезать свободный край ножницами. Материал замачивают в реагентах, с большим увеличением рассматривают под микроскопом.
Эпидермофития ногтей
Патология начинается изменениями свободного края ногтя в виде желтых полос и пятен. Затем утолщается и становится желтой вся ногтевая пластина. Она легко ломается и крошится, возникает подногтевой гиперкератоз (скапливаются роговые массы). Иногда бывает обратная ситуация: ноготь истончается и происходит его отторжение от ногтевого ложа – такой процесс называют онихолизисом. Зачастую поражаются ногтевые пластины на первом и пятом пальцах ног. Пальцы рук патологический процесс не затрагивает.
Рецепты нетрадиционной медицины
Не менее действенными станут народные методы терапии, некоторые составляющие можно приобрести в аптеке. Применение рецептов должно быть частью комплексной терапии, но никак не ее основой.
Молочно-салициловый коллодий
Для приготовления средства потребуется взять 10 г салициловой кислоты, 80 г коллодия. Составляющие интенсивно встряхивают, хранят в холодном месте (можно на дверке холодильника).
Инфицированные участки стоп смазывают утром после пробуждения, дополнительно применяют 5% салициловую мазь. Длительность курса лечения составляет от 7 до 10 суток. Благодаря применению молочной кислоты уничтожается грибок, салициловая кислота становится профилактическим средством против рассеивания спор грибка по коже. Вещество также угнетает функционирование потовых желез.
Примочки из чистотела
Для этого рецепта:
- берут 3 столовые ложки измельченной травы чистотела;
- заваривают 500 мл кипятка;
- прогревают на водяной бане в течение пары минут;
- настаивают еще час.
Полученное средство используют для ночных компрессов. Оптимальный срок лечения – 10 суток.
Врач рекомендует также смазывать чистым соком чистотела ранки, метод помогает быстрее восстановить ткани, кожа и ногти будут выглядеть здоровыми. Отвар из травы чистотела разрешается добавлять в ванночки для ног.
Важное дополнение: Чем лечить лишай у человека быстро и в домашних условиях?
Травяные сборы
Положительная динамика эпидермофитии наблюдается после применения лекарственных сборов, полезно использовать базилик и лиственницу. Необходимо взять по 100 г сырья, отмерить 3 столовые ложки смеси, залить половиной литра кипятка, проварить несколько минут на водяной бане.
В отваре парят ноги, для процедуры нужно выделить по 10-15 минут каждый вечер, курс 12 суток. Базилик оказывает противогрибковое воздействие, лиственница снимает воспалительный процесс. В раствор можно добавлять яблочный уксус.
Сода и соль
Для обработки стоп применяют солевые примочки. Для приготовления потребуется взять 2 столовые ложки морской соли, 500 мл горячей воды. Составляющие смешивают, должна получиться густая паста. Ею натирают больные участки, дают соли полностью высохнуть. Затем средство удаляют, воспаленные участки присыпают кукурузным крахмалом.
Как лечить заболевание
Сакания Луиза Руслановна
Врач-дерматовенеролог, врач-косметолог, трихолог
На более поздних стадиях развития паховой эпидермофитии, лечение предполагает комплексный подход, включающий ряд рекомендаций.
- Применение противогрибковых мазей. Сегодня фармацевтика предлагает огромное разнообразие препаратов такого направления: Клотримазол, Ламизил, Леворин, Оксиназол, Микосептин и другие.
- Обработка поражённых кожных покровов противовоспалительными средствами. Проводится, как правило, при остром течении заболевания. В этом случае назначают препараты, оказывающие комплексное действие: Миконазол, Изоконазол, Дифлукортолон или Мазипредон. Эти мази применяют до прекращения воспаления, а потом используют только противогрибковые.
- Применение антигистаминных препаратов для снижения зудящего эффекта и дискомфорта. Как правило, назначаются в виде таблеток: Супрастина, Зиртека, Тавегила, Кларитина и других.
- Подсушивающим и снижающим воспалительный процесс эффектом обладают ванны с настоями трав: ромашки, череды или коры дуба.
Лечение паховой эпидермофитии предусматривает неукоснительное соблюдение всех предписаний врача и строжайшую дисциплину для пациента. Только в этом случае становится возможным полное выздоровление.
Диагностика паховой эпидермофитии
Для диагностики микоза необходимо сделать соскоб с периферической зоны очага поражения, так как именно там грибы находятся в большом количестве. При микроскопии можно обнаружить мицелий грибов. Идентификация возбудителей проводится только при культуральном исследовании.
Рис. 26. Рост колоний грибов Epidermophyton floccosum (фото слева) и микроскопия чистой культуры (фото справа).
Дифференциальная диагностика
Паховую эпидермофитию следует отличать от рубромикоза, эритразмы, опрелости, кандидоза, псориаза, себорейной экземы, разноцветного лишая, стрептококковой опрелости.
Заразна ли эта патология
Грибковые заболевания кожи пациенты часто начинают лечить самостоятельно. Не нужно делать, поскольку на разных грибковых паразитов действуют разные лекарства.
Применяя какой-нибудь препарат без консультации врача, существует риск навредить — болезнь может остаться, перейти в запущенную стадию и вызвать ряд осложнений.
Чтобы этого не произошло, необходимо при наличии любых высыпаний на коже, сильного зуда и жжения в пораженных местах скорее обратиться к врачу.
Это будут:
- Дерматолог — врач, который лечит любые кожные патологии.
- Миколог. Это врач, который специализируется по грибковым поражениям кожи.
- Подолог — специалист с высшим образованием, который занимается лечением грибка стоп. Часто его можно встретить в косметологических салонах.
В зависимости от симптомов и степени распространения болезни необходимо обратиться к одному из них или к каждому по очереди. Они эффективно справятся с проблемой.
Паховая эпидермофития считается заразным заболеванием, поскольку пути ее передачи связаны с бытовым контактом людей.
Она передается от зараженного человека к другому человеку такими путями:
https://feedmed.ru/bolezni/kozhnye/pahovaya-epidermofitiya-zhenshhin.html
- Через прикосновения (рукопожатия, поцелуи, объятия);
- Путем совместного пользования предметами быта (посуда, столовые приборы) и личной гигиены (полотенце, мыло, мочалка);
- Из-за ношения чужой одежды и обуви.
Подцепить болезнь можно в местах общего пользования, которые связанны с непосредственным контактом между людьми. Наиболее опасными в этом плане считаются общие бани, сауны, бассейны.
Лечение ступней
Противомикозной терапии и народным средствам лечения под силу уничтожить эпидермофитию. Сложные случаи с сопутствующими болезнями и вторичными инфекциями не сдадутся от самолечения. Пациент только усугубит течение заболевания.
Препараты указаны в ознакомительных целях.
Медицинские препараты
Лечение проходит в 2 этапа:
- Удаление ороговевшего слоя, прокол пузырей.
- Снятие воспаления, заживление ран, уничтожение грибка.
Оздоровление ногтей начинается с полного удаления заражённой пластины. Терапия занимает в сумме около 2-х месяцев.
В стандартных случаях эпидермофитии обходятся наружными антигрибковыми препаратами в форме геля, мази, раствора или крема:
- Итраконазол;
- Тербинафин;
- Фукорцин;
- Клотримазол;
- Краска Кастеллани;
- Борно-цинко-нафталановая мазь;
- Ламизил;
- Тинактил;
- Мазь Ариевича.
Тербинафин — хорошее средство от грибка стопы
Последняя предназначена для снятия сухого слоя кожи. Ее наносят сразу после размягчающей содовой ванночки для ног. Щедро смазывают больные места, оборачивают целлофаном или пергаментом, надевают носки. Снимают через сутки. Обычно слой кожи легко сходит при небольшом содействии пальцами рук. Если не получается, то компресс продлевают еще на сутки. Размягчающее действие обусловлено наличием молочной и салициловой кислоты. Со старым слоем пораженной кожи убирается львиная доля грибковых спор.
Внутрь прописывают:
- антигистаминные препараты – Димедрол, Тавегил, Супрастин;
- антибиотики – Эритромецин, Цефалоспорин;
- поливитамины – по индивидуальному назначению;
- хлорид кальция внутривенно.
Для снятия ороговевших клеток кожи рекомендуют примочки из меди, цинка, ванночки с отварами аптечных трав и соды.
Тавегил используется для лечения сложной формы грибка
Лечение народными средствами
Домашние рецепты по эффективности иногда не отстают от медицинских средств. Некоторые ингредиенты приобретают в аптеке.
Молочно-салициловый коллодий
Молочно-салициловый коллодий готовят дома. Молочную и салициловую кислоту берут по 10 г и 80 г коллодия. Тщательно смешивают и хранят в холодильнике. Утром и перед сном смазывают ноги. Наилучший эффект с одновременным использованием 5% салициловой мази. Курс – 7-10 дней.
Молочная кислота пагубно действует на грибок
Салициловая кислота предупреждает рассеивание грибка по ноге за счет угнетения работы потовых желез. Смягчает ороговевший слой с тысячами клеток гриба и позволяет отслойке кожи удалить его вместе с паразитом.
Компресс и примочки из чистотела
Сухую траву чистотела (3 ст. л.) запаривают полулитром кипятка и кипятят несколько минут. Настаивают час, после чего делают компресс на ночь. Курс – 10 дней.
В дополнение можно смазывать чистым соком растения ранки для скорого заживления.
Чистотел — давнее средство для лечения грибка
Травяной отвар для ванночек
Базилик и лиственник (по 100 г) смешивают в один сбор. На пол-литра кипятка берут 3 ст. л. и проваривают пару минут. Парить ноги в отваре на протяжении 12 дней.
Базилик обладает противогрибковыми свойствами
Какой грибок вызывает эпидермофитию?
Возбудителем заболевания является грибок Epidermophyton floccosum, который образует свой микромицелий в чешуйках кожи и ногтях. Он также обнаруживается в жидких клеточных скоплениях, образующихся при разрушении тканей в результате микоза. По своей распространенности среди причин грибковых заболеваний этот возбудитель находится на 4 месте.